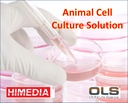

Cell Therapy Contact Us Immune Cell Therapy Stem Cell Therapy Quality Control Cell Therapy - Accelerate Discovery to Preclinical Success Cell therapy is a medical approach...

[AT261A] Iscove's Modified Dulbecco's Medium is an enriched modification of Dulbecco's Modified Eagle's Medium wherein serum can be partially or totally replaced by chemically defined substances....
[AT070A] Iscove's Modified Dulbecco's Medium is an enriched modification of Dulbecco's Modified Eagle's Medium wherein serum can be partially or totally replaced by chemically defined substances. s...

[AL070S] Iscove's Modified Dulbecco's Medium(IMDM) is an enriched modification of Dulbecco's Modified Eagle's Medium wherein serum can be partially or totally replaced by chemically defined...

[AT188] Iscove's Modified Dulbecco's Medium is an enriched modification of Dulbecco's Modified Eagle's Medium wherein serum can be partially or totally replaced by chemically defined substances....

[AT070] Iscove's Modified Dulbecco's Medium is an enriched modification of Dulbecco's Modified Eagle's Medium wherein serum can be partially or totally replaced by chemically defined substances....

[AL160A] Iscove's Modified Dulbecco's Medium(IMDM) is an enriched modification of Dulbecco's Modified Eagle's Medium wherein serum can be partially or totally replaced by chemically defined...

[AT160] Iscove's Modified Dulbecco's Medium is an enriched modification of Dulbecco's Modified Eagle's Medium wherein serum can be partially or totally replaced by chemically defined substances....

[AL070A] Iscove's Modified Dulbecco's Medium(IMDM) is an enriched modification of Dulbecco's Modified Eagle's Medium wherein serum can be partially or totally replaced by chemically defined...

[AL070H] Iscove's Modified Dulbecco's Medium(IMDM) is an enriched modification of Dulbecco's Modified Eagle's Medium wherein serum can be partially or totally replaced by chemically defined...

[AL070] Iscove's Modified Dulbecco's Medium(IMDM) is an enriched modification of Dulbecco's Modified Eagle's Medium wherein serum can be partially or totally replaced by chemically defined...

[AL230A] Iscove's Modified Dulbecco's Medium(IMDM) is an enriched modification of Dulbecco's Modified Eagle's Medium wherein serum can be partially or totally replaced by chemically defined...